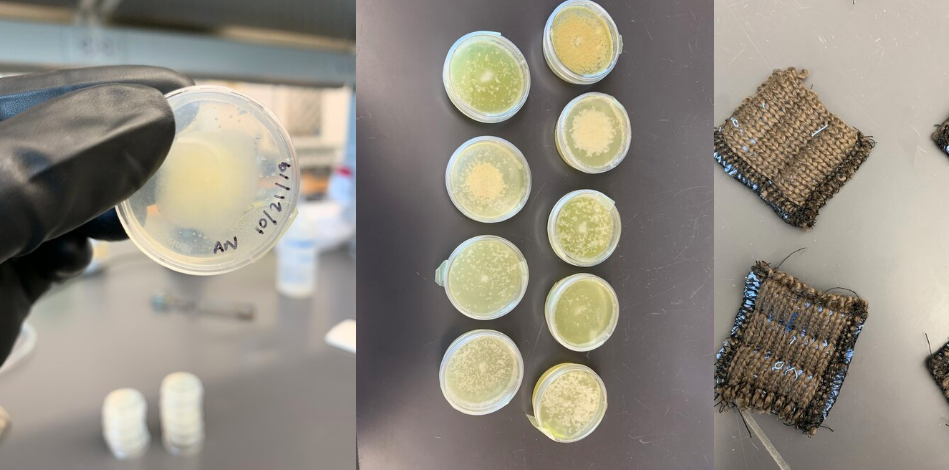
Biodesign team Embrace the Mold image of fungal cultures and inoculated textiles, Image copyright Bioblack

What is ESDRI doing as part of the Biodesign theme year?
A range of ESDRI activities this year will engage students, faculty, and the public in the Biodesign theme.
Biodesign Challenge Course

In Fall 2019, twenty-four students from seven majors (including Fashion, Biology, and Architecture) worked in interdisciplinary teams on Biodesign projects. That’s right – Fashion students worked with plants, algae, and bacteria, while Biology students saw their ideas beautifully sketched by artists or rendered using 3D modeling software. It was a unique experience for an advanced college course, although not at all unusual in the outside world. Students collaborated with others with very different training, while flexing the skills they had learned in previous discipline-specific courses.
Teams developed biodesign projects throughout the semester, using design thinking principles coupled with biological tools. Together, four of the projects amount to a reimagining of the fashion industry, from biological dyes and materials, to clean manufacturing facilities, to bio-driven post-consumer recycling of clothes. Two other projects addressed new systems for clean water, food, and energy production.

Concepts or products from all teams will be on display at the ESDRI Symposium in March. As part of the coursework, the student teams created websites to showcase their projects. One team will also represent Kent State University at the international Biodesign Challenge Summit in June 2020, competing against schools from around the world.
The students were enrolled in a team-taught course that was a collaboration between ESDRI, Design Innovation, the College of Architecture and Environmental Design, KSU Fashion, and the Department of Biological Sciences.

Biologically stained textile. Image copyright Bioblack.
Fungal cultures and textile inoculation. Image copyright Embrace the Mold.

Rendering of home food production and water filtration ecosystem. Image copyright MECA.

Filamentous algal culture. Image copyright Algae Facade.

Rendering of sculpture for textile wastewater remediation, Image copyright Dyeing Rivers.

Rendering of deep sea biofuel production system. Image copyright Algae Crushers.
2019/2020 ESDRI Visiting Lecturer
Maria Paz Gutierrez, Associate Professor in the College of Environmental Design at the University of California at Berkeley, has visited Kent State University twice so far this year to give a public presentation, provide guidance, and act as a juror to our students enrolled in the Biodesign Challenge course, as well as meeting with multiple faculty and students. She will be back to give a morning address at the 2020 ESDRI Symposium in March.

Gutierrez is an architect and researcher focused on nature and multifunctional material systems aimed at addressing pressing 21st century environmental and socioeconomic challenges. Her research group, BIOMS, pioneers the physical and cultural implication of functional natural and living materials. These functional natural materials are designed from the nano to the macro scale to transform the health and resilience of the built environment. For example, at the nano scale, past projects have included development of bio-active building materials for grey water reuse, dynamic control of thermal and light transmission, and air detoxification. At the macro scale, she has developed adaptable infrastructures in coastal tropical and urban habitats for flood self-regulation, energy generation, hydro desalinization, and aquaculture regeneration.
Her work has been published in leading scientific journals, including Science and Scientific Reports (Nature), exhibited nationally and internationally, and widely covered in the press, including in Science Nation. Her exhibitions include the Oslo Architectural Triennale 2014 and the Field Museum in Chicago. Gutierrez’s prestigious accolades include the 2010 Emerging Frontiers of Research Innovation Award from the U.S. National Science Foundation 2014 Buckminster Fuller Award semifinalist. Gutierrez is a Fulbright NEXUS Scholar and was appointed as Senior Fellow of the Energy Climate Partnership of the Americas by the U.S. Department of State from 2011-2016. Gutierrez has two provisional patents and a forthcoming book, Regeneration Wall (Taylor & Francis, 2020).
Additional info on Professor Guttierez:
https://www.youtube.com/watch?v=nS_HgfanRjA
https://www.youtube.com/watch?v=6Xe0aiHBHHY
https://ced.berkeley.edu/ced/faculty-staff/m-paz-gutierrez
http://www.bioms.info/news.html
2020 Environmental Science and Design Symposium

Beginning with the Water Symposium in 2014, Kent State has annually hosted a conference on environmental issues critical to our region and the globe. Now called the Environmental Science and Design Symposium, this year the event will be held March 16-18, 2020. The theme of Biodesign will be highlighted in several ways, while the symposium will also be of interest to anyone with concerns about environmental issues. Biodesign can serve as the interface between environmental science, design, social science, art, and sustainability. This university-wide focus brings together faculty from multiple departments and nearly 40 different degree programs to explore what it means to move into a sustainable, future society. In developing this year’s symposium – focused on the complexity of designing with biology – we recognized that this interdisciplinary challenge warranted our featuring a variety of speakers from areas of specialization.

Our symposium will open on March 17 with a world-renowned Biodesign expert and keynote speaker, Rachel Armstrong from Newcastle University, U.K. On March 18, we will be hosting talks in the morning including by Paz Gutierrez (Berkeley University, speaking on building materials Biodesign), Christie Bahlai (Kent State University, speaking on green roof ecology), Lauren McPhillips (Penn State University, speaking on wetland performance and design), and Elena Brebenel (Kent State University, speaking on biomaterial art and textiles). This will be followed by an afternoon session introducing the Design Innovation program at Kent State, and breakout sessions on the future of biodesign, wetlands, and green roofs. Finally, the late afternoon/early evening features a general research poster session and opportunities for student recruitment and interviews.

